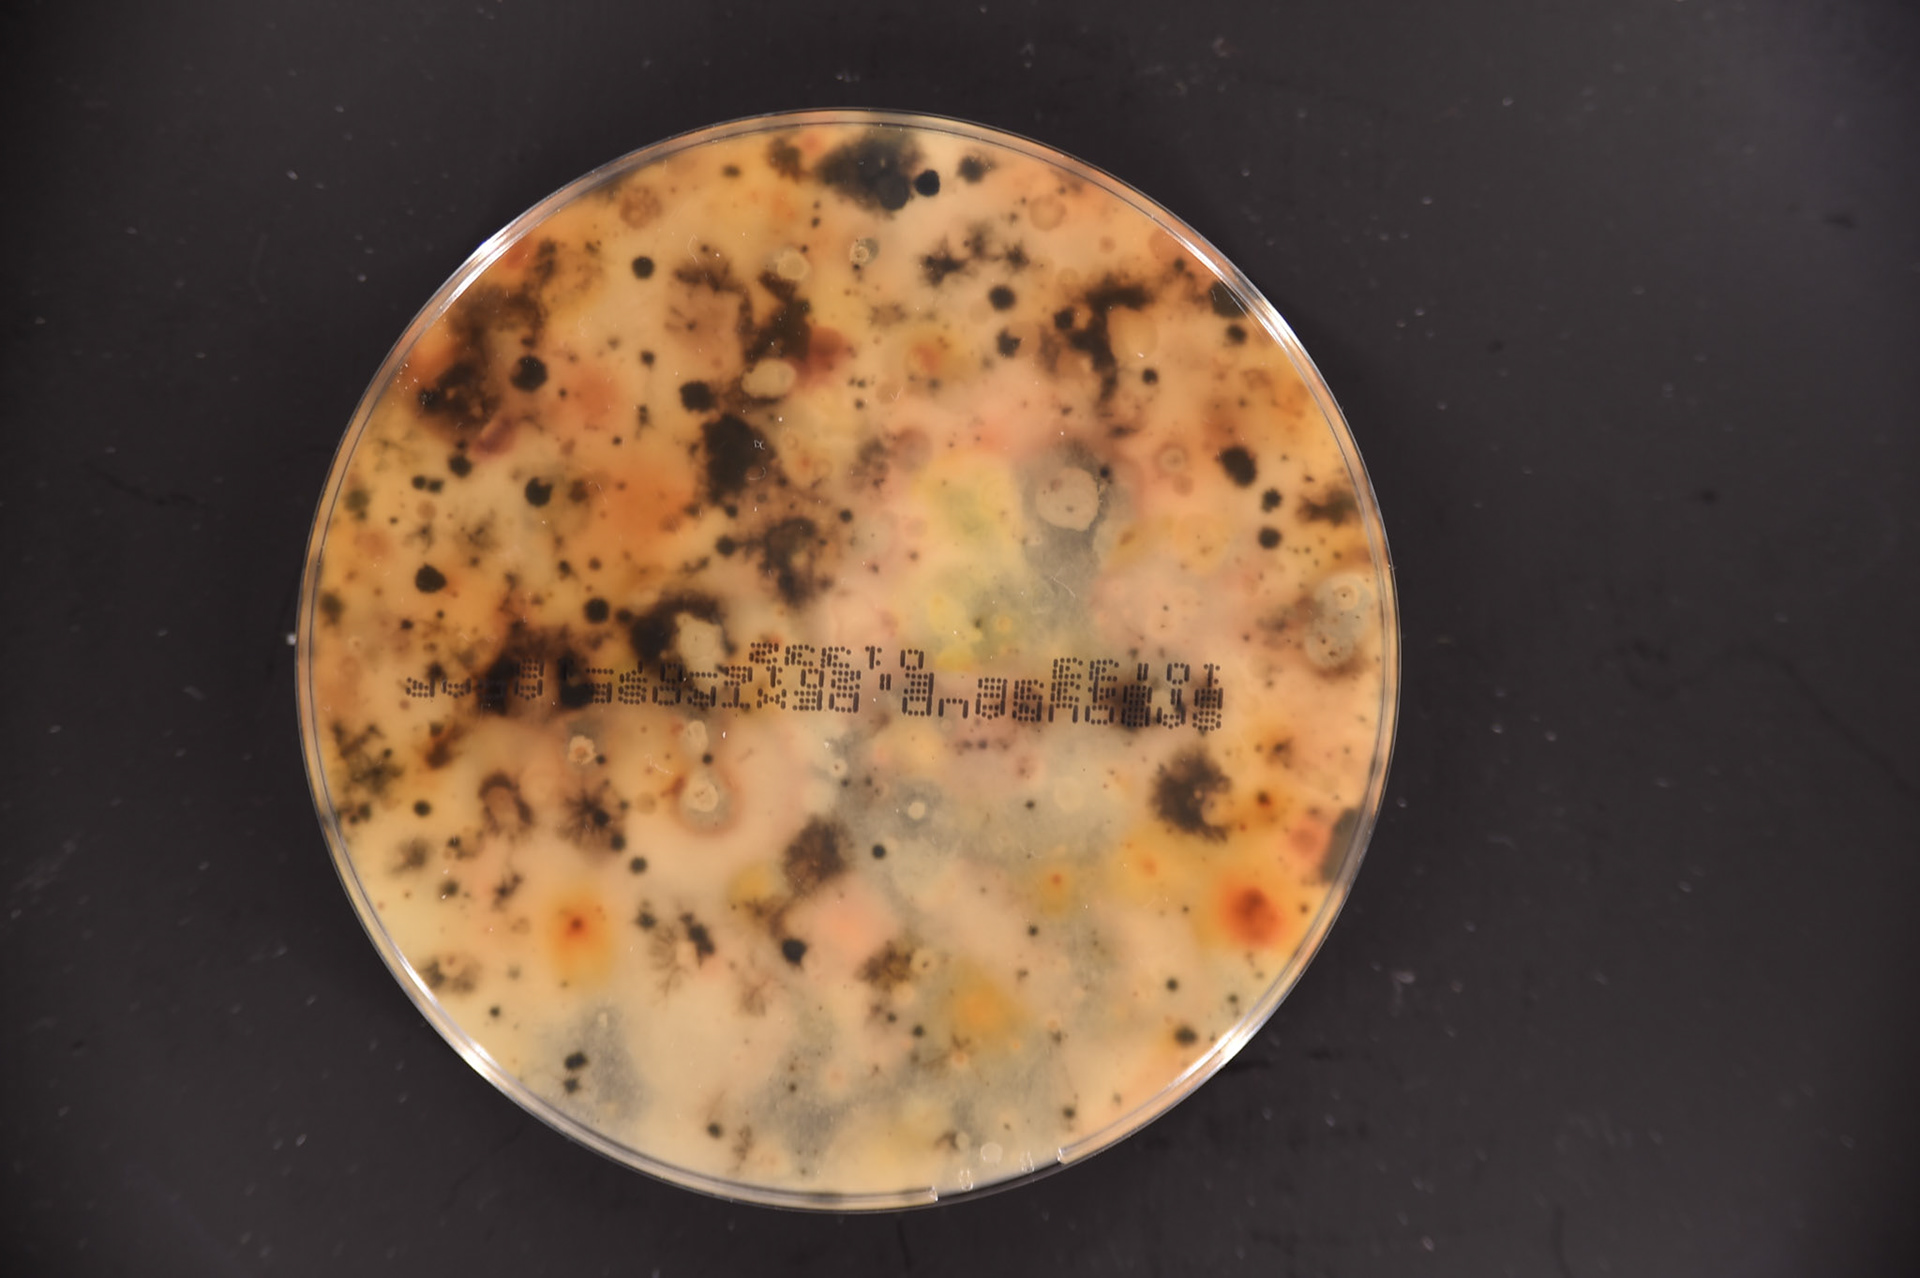

Vanessa Lorenzo.
A collaborative art-design-research project powered by @Sabadell @MedialabPrado as part of "manual for earthly survival" and based on a speculative project (cooked at @Hackuarium biohackerspace as a part of speculative design for @HEAD Genève) that actually turned into a real/feasible/enginered project see https://vlorenzolana.myportfolio.com/prinkt-plastic-its-fantastic "Biofilia Urbana" dig into posible biomaterials that we can find in different places, making possible to culture them to print a microedition of each place's microbiodiversity with a hacked 3D printer. The exploration of the poetic visual link that people's and places' bacteria and fungi can reveal. Is not only about future biomaterials, is also about multiespecies metarelations and simbiosis. CREDITS: SABADELL, MEDIALAB PRADO, FABLAB MEDIALAB, Sibley Labandeira, Daniel Pietrosemoli, Javier Villaroel, Mar Delgado. THANKS TO: Hackuarium, Joanna Chicau, Raimon Guarro i Nogués, Servando Barreiro, Carlos Garate Marqueterie, Chema Blanco and other citizen collaborators of Madrid that spontaneously join the experience. Also special thanks to all the cultural mediation Team from Medialab Prado that helped me searching moss, bacteria and fungi all over the region of Madrid and Sepulveda in July 2016. GITHUB collaborator: Javier Villaroel https://github.com/Vlorenzolana/BiofiliaUrbana https://github.com/JavierVLAB